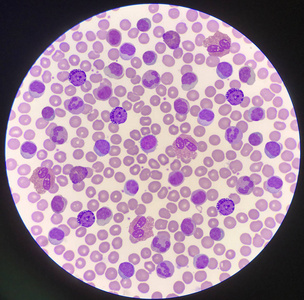
混合成熟白细胞在红细胞背景上.照片

镜下白细胞红细胞图片
![[尿镜检]白细胞管型红细胞管型傻傻分不清 94把镜下白细胞和红细胞](https://imgs.wantubizhi.com/img/735A5D1F980B52A636CC46F12F2D1A731B788F0139BD639AEF26DC814F35E37A15AE7916F65621926969F3430B3F7AFDE32BE775B960B447A1B89FDCF75E84943792017D9C7D92782A0A5B016FC1DF88CDB950A27AAD02A41A3EC090FBCAED08)
[尿镜检]白细胞管型红细胞管型傻傻分不清 94把镜下白细胞和红细胞
图片尺寸1707x1280
白带镜检之红细胞 手抖拍的不是很清楚
图片尺寸960x1280
白细胞_红血球_背景_图片大全—全景创意图库(quanjing.
图片尺寸794x790
红细胞背景上的白细胞.照片
图片尺寸306x300
红细胞 白细胞 血细胞
图片尺寸1080x810
生物显微镜标本切片红细胞白细胞显像清晰易观察显微玻片 人血涂片瑞
图片尺寸350x350
混合成熟白细胞在红细胞背景上.照片
图片尺寸304x300
显微镜下观察红细胞&白细胞
图片尺寸640x569
该份粪便标本外观为红色,软便,40倍镜下可见大量红细胞及白细胞,如图2
图片尺寸776x573
新鲜红细胞,尿液检查白细胞.
图片尺寸1100x1109
校正后的白细胞数/l=100/(100 有核红细胞数) ×校正前白细胞数 3
图片尺寸640x480
小细胞低色素性轻度贫血,直接审核掉?
图片尺寸552x738
正常人血液中的红细胞多(小圆球样)白细胞数目很少(2个)
图片尺寸504x331
今天学习看尿液中的白细胞和红细胞
图片尺寸1080x810
校正后的白细胞数/l=100/(100 有核红细胞数) ×校正前白细胞数 3
图片尺寸640x480
血涂片检查_白细胞
图片尺寸330x450
白细胞与红细胞怎样用显微镜反光镜区别
图片尺寸1280x1158
白细胞增多血涂片镜检尿道感染红白细胞增
图片尺寸1080x809
是红是白还是虫,这张图帮你搞定!|红细胞|原虫|镜检|致病力_网易订阅
图片尺寸660x880
血红细胞与白细胞背景
图片尺寸700x463
![[尿镜检]白细胞管型红细胞管型傻傻分不清 94把镜下白细胞和红细胞](https://imgs.wantubizhi.com/img/735A5D1F980B52A636CC46F12F2D1A731B788F0139BD639AEF26DC814F35E37A15AE7916F65621926969F3430B3F7AFDE32BE775B960B447A1B89FDCF75E84943792017D9C7D92782A0A5B016FC1DF88CDB950A27AAD02A41A3EC090FBCAED08)















![[尿镜检]白细胞管型红细胞管型傻傻分不清 94把镜下白细胞和红细胞](https://b0.bdstatic.com/f50f7d03f092a60c67867631ac7c3c27.jpg@h_1280)